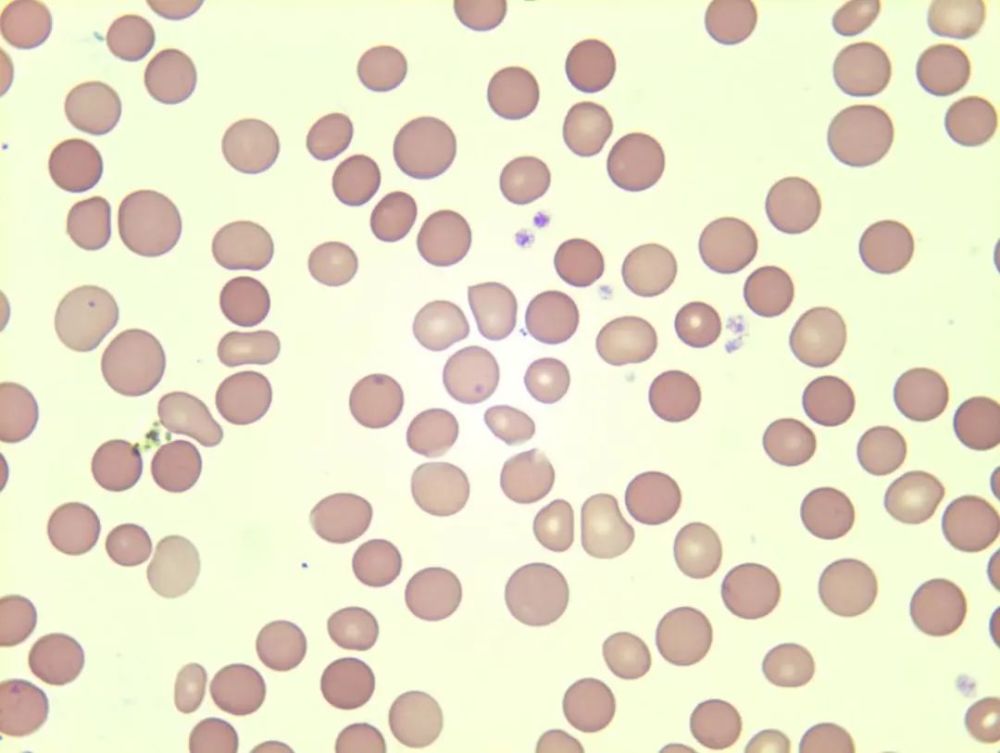
图为球形红细胞增多 提示遗传性球形红细胞增多症等

红血球3803

自截自调红血球篇
图片尺寸1038x1038
p>红细胞也称红血球,在常规化验中英文常缩写成rbc,是血液中数量最多
图片尺寸1200x805
红血球
图片尺寸467x350
红色的血液细胞
图片尺寸700x466
请问大家知不知道为什么会出现如图的情况,血液是在患
图片尺寸1024x1024
科普详情
图片尺寸5760x3162
红血球,高,特写,风景,血细胞
图片尺寸519x350
第三位:红细胞(ae3803),《工作细胞》审判换个角度来说就是一场cp争夺
图片尺寸1142x641
个人手绘战斗型红细胞ae3803
图片尺寸650x650
们对抗肺炎链球菌的入侵,画面围绕主角新人红细胞编号ae3803来展现
图片尺寸640x432
黏土人#1214 工作细胞 红血球 ae3803
图片尺寸700x1033
第一名:红血球(ae3803),《工作细胞》下面看具体排名
图片尺寸690x423
一个个四处奔忙的搬运工,而作为主人公的红细胞"ae3803"虽然时常迷路
图片尺寸1080x608
红细胞红血球
图片尺寸1280x853
人体红血球(显微照片)2009年
图片尺寸751x529
教你画q版红血球线稿临摹自ibuchuan
图片尺寸720x820
图为球形红细胞增多 提示遗传性球形红细胞增多症等
图片尺寸1000x753
3d渲染红血球背景.照片
图片尺寸449x300
鸿汇医药网-浙江鸿汇医药物流有限公司
图片尺寸800x800
黏土人#1214 工作细胞 红血球 ae3803
图片尺寸800x600